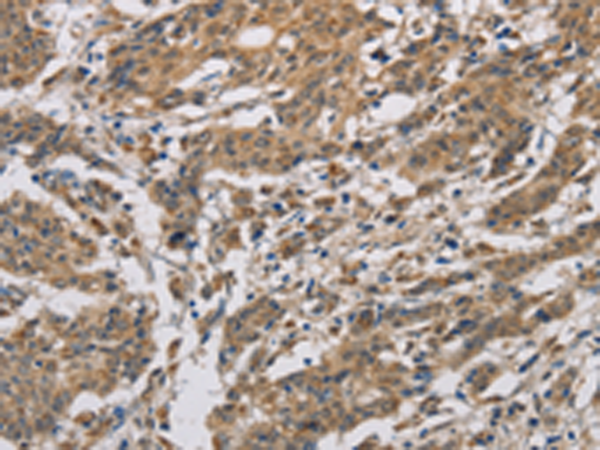
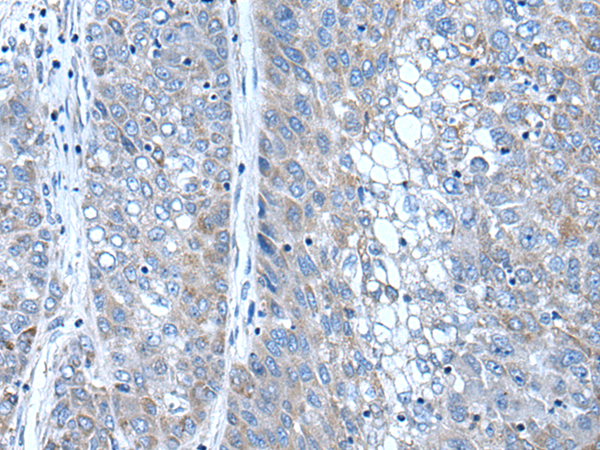
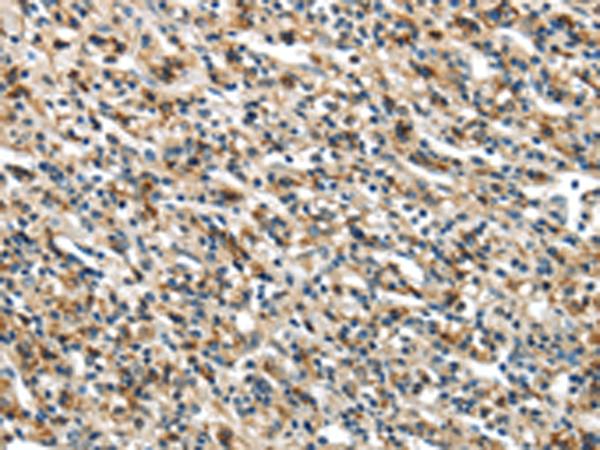

-
分类: 科研抗体货号: P00332别名: SGY; CT34; SGY1; SGY-1应用: WB反应种属: Human, Mouse
-
分类: 科研抗体货号: P00359别名: MKP3, PYST1应用: WB,IHC反应种属: Human, Mouse, Rat
-
分类: 科研抗体货号: P00315别名: DBDR, DRD1B, DRD1L2应用: WB,IHC反应种属: Human
-
分类: 科研抗体货号: P00331别名: RIG; REIC应用: IHC反应种属: Human, Mouse
-
分类: 科研抗体货号: P00356别名: SKRP1; DUSP17; LMWDSP3; TS-DSP1应用: IHC反应种属: Human, Mouse
-
分类: 科研抗体货号: P00314别名: CYC; HCS; THC4应用: WB,IHC反应种属: Human, Mouse, Rat
-
分类: 科研抗体货号: P00405别名:应用: WB,IHC反应种属: Human, Mouse, Rat
-
分类: 科研抗体货号: P00351别名: FRP-4; FRPHE; sFRP-4应用: IHC反应种属: Human, Mouse, Rat
-
分类: 科研抗体货号: P00312别名: CP1B; GLC3A; CYPIB1; P4501B1应用: IHC反应种属: Human, Mouse, Rat
-
分类: 科研抗体货号: P00401别名:应用: WB,IHC反应种属: Human, Mouse

鄂公网安备42018502007531号
鄂公网安备42018502007531号

